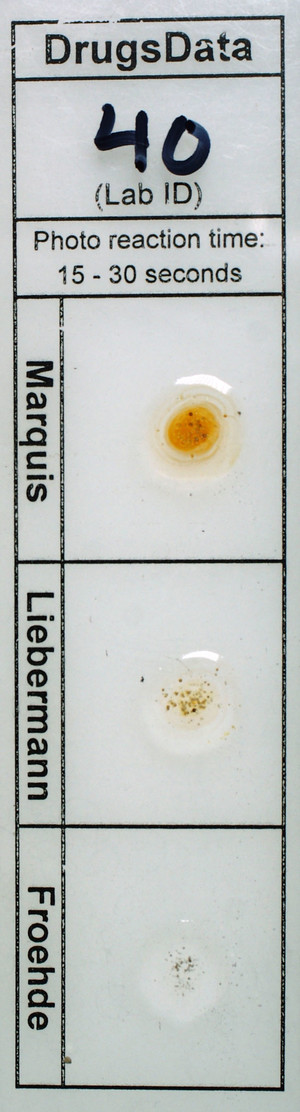
Detail Photo

New Submissions Are Not Currently Being Accepted
Samples sent after April 10, 2024 will be put on hold.
Viewing desktop version: Switch to Mobile
Fetty
Sold as: Fentanyl
ID: 16775
| ID: | 16775 |
|---|---|
| Name: | Fetty |
| Other Names: | |
| UniqueCode: |
AC2023B2277 |
| Marquis: |
Orange |
| Liebermann | Light Brown |
| Froehde | No Reaction |
| Fentanyl Test Strip (FTS): | Positive |
| GC/MS: |
|
Sold as: Fentanyl
Expected to be: Fentanyl
Has Been Tried: No
Sugars / Diluents Detected
The lab identified sugars or diluents in this sample:
Mannitol
Description
Off-white powder in baggie.